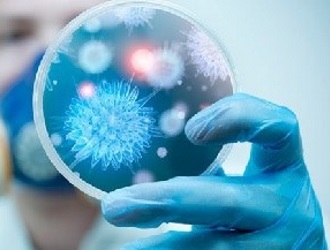
Паралитический тип вируса является наиболее опасным

Полиомиелит — вирусное заболевание, в основном затрагивающее детей, но последствия могут касаться и взрослых. В последние десятилетия случаи полиомиелита у взрослых становятся более распространёнными, что требует внимания к симптомам, причинам и методам лечения. В статье рассмотрим ключевые аспекты полиомиелита у взрослых: пути передачи вируса, возможные осложнения и меры профилактики. Понимание этих вопросов поможет распознать заболевание на ранней стадии и предпринять необходимые шаги для его предотвращения и лечения.
Что такое полиомиелит?
Полиомиелит — это вирусное заболевание, которое негативно влияет на серое вещество спинного мозга. Его также называют детским спинальным параличом или болезнью Гейне-Медина.
Основным возбудителем полиомиелита является полиовирус poliovirus hominis, который атакует слизистую оболочку кишечника, носоглотки и нервную систему. Обычно инфекция проникает в организм через фекально-оральный путь.
Вирус полиомиелита поражает серое вещество спинного мозга
Заражение может произойти через грязные руки или общие предметы. После попадания в организм вирус начинает размножаться в носоглотке и миндалинах, а затем проникает в пищеварительный тракт, где может находиться в фекальных массах.
Если вирус достигает лимфоузлов (например, шейных или брыжеечных), существует высокая вероятность его попадания в кровоток, что может привести к заражению спинного и головного мозга.
Врачи отмечают, что полиомиелит у взрослых, хотя и встречается реже, чем у детей, может иметь серьезные последствия. Основной причиной заболевания является вирус, который передается фекально-оральным путем. Симптомы могут варьироваться от легкой лихорадки и головной боли до более тяжелых проявлений, таких как паралич. Врачи подчеркивают важность ранней диагностики, так как это позволяет начать лечение на ранних стадиях. Основные методы лечения включают симптоматическую терапию, физическую реабилитацию и, в некоторых случаях, антивирусные препараты. Профилактика остается ключевым аспектом, и вакцинация продолжает быть самым эффективным способом защиты от вируса. Врачи настоятельно рекомендуют следить за своим здоровьем и обращаться за медицинской помощью при первых признаках заболевания.
https://youtube.com/watch?v=lYjajDKoYh0
Классификация заболевания
Существует несколько типов полиомиелита:
- Абортивный. Протекает без выраженных симптомов и не затрагивает нервную систему;
- Непаралитический;
- Менингеальный;
- Паралитический. Может возникнуть на фоне других форм полиомиелита;
- Спинальный;
- Потинный. Вирус воздействует на ядра черепных нервов, что приводит к параличу мимических и жевательных мышц;
- Бульбарный. Чаще всего наблюдается у взрослых. Затрагивает головной мозг;
- Энцефалитический. Редкая форма заболевания;
- Периферический;
- Инаппаратный. Человек не испытывает симптомов болезни, но выступает в роли носителя вируса.
None
История заболевания
Изучение полиомиелита началось в середине 19 века. Первым, кто обратил внимание на этот вирус, стал немецкий врач Гейне. В 1840 году он опубликовал свои первые исследования, посвященные этому заболеванию.
После Гейне к исследованию подключились русский невропатолог Кожевников и шведский педиатр Медин. Им удалось установить, что инфекция является самостоятельной и заразной. Однако эффективные методы борьбы с вирусом были разработаны значительно позже.
Разработка вакцины против полиомиелита стартовала в СССР. Группа ученых, включая Чумакова, Николаеву и Смородинцева, смогла выделить вирус и создать на его основе работоспособную вакцину.
Вскоре в США А. Сэйбин, Д. Солк и Х. Копровский разработали препараты, которые помогли решить проблему массового заражения. Эти исследования стали основой для широкомасштабной вакцинации. К началу 60-х годов 20 века заболеваемость полиомиелитом сократилась почти в шесть раз, а затем этот вирус стал встречаться крайне редко (всего около 100 случаев по всему миру).
СССР стал первой страной, которая полностью победила полиомиелит, не зарегистрировав ни одного случая заболевания. М. П. Чумаков основал НИИ, где активно производилась вакцина, поставляемая во все страны социалистического лагеря и в Японию.
Западные страны смогли справиться с вирусом несколько позже. В 1994 году полиомиелит был побежден и там, а в Европе это событие произошло только в 2002 году.
Полиомиелит у взрослых — это редкое, но серьезное заболевание, которое вызывает вирус полиомиелита. Многие люди считают, что полиомиелит — это проблема только для детей, однако взрослые также могут столкнуться с его последствиями. Основные причины заболевания у взрослых связаны с ослаблением иммунной системы, что может произойти после вакцинации в детстве или в результате других инфекций. Симптомы полиомиелита могут варьироваться от легкой лихорадки и головной боли до более серьезных проявлений, таких как паралич. Лечение в основном симптоматическое и направлено на облегчение состояния пациента, включая физиотерапию для восстановления двигательных функций. Важно помнить, что профилактика через вакцинацию остается наиболее эффективным способом защиты от этого заболевания. Обсуждение полиомиелита у взрослых подчеркивает необходимость осведомленности о рисках и важности своевременного обращения к врачу при появлении первых симптомов.
https://youtube.com/watch?v=ffEzdTg4YB4
Код по МКБ
Полиомиелит имеет код А80 в Международной классификации болезней 10-го пересмотра.
Распространенность
С момента, когда вакцинация против полиомиелита стала обязательной и широко распространенной, уровень заболеваемости значительно уменьшился. Согласно статистическим данным, полиомиелит выявляется лишь у 1% пациентов по всему миру.
В настоящее время более 80% населения Земли живет в регионах, которые официально сертифицированы как свободные от полиомиелита. Более 17 миллионов людей были спасены от паралича, а благодаря введению витамина А во время иммунизации медицинские работники смогли предотвратить свыше 2 миллионов случаев гибели детей.
https://youtube.com/watch?v=Mf-G5pgEvPE
Причины полиомиелита
Полиомиелит в настоящее время встречается довольно редко, особенно среди взрослых. Наиболее уязвимую категорию составляют дети младше 5 лет, которые не были вакцинированы или имеют врожденные нарушения иммунной системы.
Основные способы передачи вируса полиомиелита включают фекально-оральный механизм, что означает, что инфекция может передаваться через загрязненные руки, некачественные продукты, воду или общие предметы.
Вирус может размножаться и находиться в различных участках организма: миндалинах, кишечнике, лимфатических узлах и в крови. Кроме того, вирус может передаваться непосредственно от инфицированного человека.
Носитель вируса может не проявлять симптомов, но при этом оставаться источником инфекции. По мере своего развития вирус способен проникать в центральную нервную систему, затрагивая спинной и головной мозг.
Интервал между заражением и появлением первых симптомов составляет примерно 10-15 дней. Однако бывают случаи с очень коротким инкубационным периодом (до 3 дней) и с длительным (до 3 месяцев).
Последствия полиомиелита
Своевременное обращение за медицинской помощью может предотвратить серьезные последствия, связанные с развитием полиомиелита. Это особенно актуально для непаралитической формы заболевания.
Если же человек заразился паралитической формой вируса полиомиелита, то существует высокая вероятность возникновения мышечной атрофии, деформаций, а также возможен летальный исход.
Даже если удалось остановить прогрессирование вируса, нельзя исключать наличие остаточных осложнений: пациент может потерять некоторые функции и стать инвалидом. В таких случаях необходима длительная реабилитация, которая поможет восстановить или хотя бы улучшить утраченные функции.
Люди, прошедшие вакцинацию, заболевают полиомиелитом крайне редко, и даже если это происходит, болезнь протекает в легкой форме, а риск возникновения осложнений практически отсутствует.
Симптомы полиомиелита
Полиомиелит крайне редко встречается среди взрослых. Если же взрослый человек заболевает, это может свидетельствовать о том, что вирус находился в его организме на протяжении многих лет. Однако такие случаи составляют лишь незначительную долю от общего числа людей на Земле.
Симптоматика может варьироваться в зависимости от типа заболевания.
Предлагаем ознакомиться с симптомами всех форм полиомиелита.
Непаралитический полиомиелит
- У пациента фиксируется высокая температура (40ºС);
- Наблюдаются мышечные боли;
- Имеется общее недомогание;
- Аппетит отсутствует;
- Имеются рвота и тошнота;
- Пациент испытывает головную боль;
- Отмечается боль в горле;
- Проявляются эмоциональные колебания, раздражительность;
- Зафиксирована ригидность шейных и спинных мышц;
- Подозрение на менингит;
- Все перечисленные симптомы могут активно развиваться в течение двух недель, после чего наблюдается их ослабление.
Абортивный полиомиелит
- Повышенная температура (38-39º);
- Общая усталость;
- Головная боль;
- Боль в области живота;
- Кашель и насморк;
- Рвота;
- Покраснение горла;
- Гастроэнтерит;
- Энтероколит;
- Катаральная ангина;
- Признаки кишечного токсикоза, напоминающие дизентерию;
- Все проявления усиливаются на протяжении недели.
Менингеальный полиомиелит
- Повышенная температура тела;
- Общее недомогание, мышечная слабость;
- Уменьшение аппетита;
- Боли в животе различной интенсивности;
- Тошнота и рвота;
- Насморк и кашель;
- Покраснение горла, миндалины и небо покрываются налетом;
Через два дня симптомы могут ослабнуть или исчезнуть полностью, однако спустя три дня возможно повторное проявление с такими признаками, как:
- Интенсивные головные боли;
- Ухудшение общего состояния;
- Появление болей в ногах и спине;
- Сильная рвота и признаки обезвоживания (симптоматика напоминает менингит).
Паралитический полиомиелит
Паралитический тип вируса представляет собой наиболее угрожающий вариант. Он проявляется следующими симптомами:
- Сокращения в мышцах, судороги, общая слабость и болезненные ощущения в мышцах;
- Снижение температуры тела (после резкого повышения при предыдущих формах заболевания);
- Увеличение мышечной слабости;
- Понижение мышечного тонуса и рефлексов;
- Появление парестезии (нарушение чувствительности, ощущение покалывания, «мурашек», онемение);
- Со временем все эти проявления могут ослабевать, однако остаются такие последствия, как деформации суставов, паралич, атрофия мышц и/или искривление позвоночника.
Спинальный полиомиелит
- Повышенная температура тела;
- Общее недомогание, усталость, сонливость;
- Слабость в мышцах;
- Головные боли;
- Раздражительность и повышенная нервозность;
- Боли в ногах;
- Наблюдаются симптомы, схожие с ринитом, фарингитом или бронхитом;
- Асимметричный паралич;
- Сниженный тонус мышц;
- Уменьшение рефлексов сухожилий.
Потинный полиомиелит
- Наблюдается несимметричное положение лицевых мышц;
- Уголок губ приподнимается на здоровой стороне;
- Веки не полностью закрываются;
- Носогубные складки становятся менее выраженными;
- Глаза выглядят более открытыми;
- На лбу исчезают горизонтальные морщины.
Бульбарный полиомиелит
- Проблемы с глотанием;
- Изменения в голосе (возникает хрипота, появляются вибрации);
- Нарушения сосудистого тонуса;
- Затруднения с дыханием;
- Появление икоты;
- Синюшность слизистых и кожи;
- У пациента отмечается повышенная тревожность и беспокойство;
- Развивается вегетососудистая дистония.
Энцефалитический полиомиелит
- Замешательство в сознании;
- Двигательная активность становится ограниченной;
- Наблюдаются судороги;
- Нарушения речи;
- Непроизвольные движения разных групп мышц;
- Коматозное состояние или ступор;
- Вегетативная дисфункция.
Диагностика заболевания
Сложность диагностики полиомиелита заключается в том, что его симптомы могут напоминать проявления других вирусов, таких как герпевирусы и энтеровирусы. На начальных этапах важно исключить такие заболевания, как клещевой энцефалит, синдром Гийена-Барре, миелит и серозный менингит.
Часто бывает сложно установить диагноз полиомиелита, особенно если он протекает в непаралитической или препаралатической форме, когда симптомы поражения нервной системы еще не проявились или отсутствуют.
Для точного определения наличия вируса полиомиелита в организме пациента проводится ряд лабораторных исследований:
- ПЦР (полимеразная цепная реакция) — позволяет обнаружить вирус в спинномозговой жидкости и фекалиях;
- ИФА (иммуноферментный анализ) — выявляет РНК полиовируса;
- Серологический анализ плазмы;
- КТ, МРТ, клинический анализ спинномозговой жидкости и электроэнцефалограмма — помогают обнаружить изменения в головном и спинном мозге.
Видео: «Симптомы полиомиелита»
Лечение полиомиелита
К сожалению, не существует универсального лечебного протокола для борьбы с полиомиелитом. С момента создания вакцины медицина больше не требует курсового лечения этого вируса. В случае, если у пациента диагностируется полиомиелит, используются препараты, которые помогают справиться с конкретными симптомами заболевания.
Медикаментозное лечение
Медикаменты применяются для облегчения некоторых симптомов полиомиелита. Обычно пациентам с этим заболеванием назначают следующие категории препаратов:
- Обезболивающие;
- Жаропонижающие средства;
- Седативные препараты;
- Нестероидные противовоспалительные средства (НПВС);
- Антигистамины;
- Средства для детоксикации.
Кроме указанных групп, могут быть назначены диуретики, антибиотики, антигипоксанты, иммуноглобулины и препараты, способствующие улучшению нервно-мышечной проводимости.
Важно также следить за положением пациента. Если у него развивается паралич, его необходимо уложить на жесткую поверхность без подушек.
Ноги следует слегка согнуть в коленях и тазобедренных суставах, располагая их параллельно. Стопы фиксируются шиной в физиологически нормальном положении. Руки нужно развести в стороны и согнуть в локтях под прямым углом.
При наличии нарушений дыхательной системы пациента подключают к аппарату искусственной вентиляции легких.
После завершения медикаментозной терапии начинается период восстановления, который включает в себя лечебную физкультуру, водные процедуры, физиотерапию и массаж.
Восстановительный период
В зависимости от типа полиомиелита, который был выявлен у пациента, разрабатываются реабилитационные мероприятия: лечебная физкультура, водные процедуры, физиотерапия, массаж.
Каждое из этих восстановительных мероприятий назначается исключительно лечащим врачом с учетом индивидуальных особенностей пациента и клинической ситуации. Все процедуры проводятся только под контролем квалифицированных специалистов.
Профилактика заболевания
В отношении полиомиелита оптимальным способом профилактики является регулярная вакцинация. Она формирует стойкий иммунитет к вирусу полиомиелита на всю жизнь. Вакцинация осуществляется сначала с использованием инактивированной вакцины, а затем живой. Расписания вакцинации могут варьироваться в зависимости от страны.
Наиболее действенной мерой против полиомиелита является своевременная вакцинация. Обратите внимание на расписание проведения прививок.
Прогноз выздоровления
Непаралитическая форма болезни, как правило, не приводит к серьезным последствиям и проходит довольно быстро при условии своевременного лечения.
Паралитическая форма, в свою очередь, представляет собой большую угрозу. Осложнения, возникающие после паралитической формы полиомиелита, могут существенно повлиять на качество жизни пациента и даже привести к смерти.
В случае, если пациент получает инвалидность, ему назначается длительный курс реабилитации, после которого в большинстве случаев удается восстановить некоторые важные функции организма.
Видео: «Можно ли вылечить полиомиелит?»
Заключение
Полиомиелит в настоящее время считается редким заболеванием. С момента появления вакцины случаи его диагностики значительно сократились. Однако отдельные эпизоды полиомиелита все еще фиксируются в некоторых странах Африки, а также в Афганистане и Пакистане.
Тем не менее, стоит обратить внимание на несколько ключевых аспектов этого вируса:
- Наиболее уязвимыми к полиомиелиту являются дети в возрасте от 6 месяцев до 4-5 лет. В этом возрасте их иммунная система еще не полностью развита и не способна эффективно бороться с большинством вирусов. Поэтому крайне важно своевременно вакцинировать ребенка, чтобы предотвратить возможные проблемы в будущем;
- Существует несколько форм полиомиелита. Из-за схожести симптомов с другими вирусными заболеваниями, иногда бывает сложно установить диагноз полиомиелита;
- Лабораторные исследования остаются наиболее надежным методом диагностики. Только они могут точно подтвердить или опровергнуть наличие вируса полиомиелита в организме пациента;
- Специальных методов лечения полиомиелита не существует. Появление вакцины сделало разработку лекарств, направленных на уничтожение этого вируса, нецелесообразной. Лечение, как правило, сосредоточено на облегчении конкретных симптомов;
- Реабилитация после перенесенного полиомиелита является важным этапом. В зависимости от индивидуальной клинической ситуации разрабатывается комплекс восстановительных мероприятий.
Профилактика и вакцинация против полиомиелита
Профилактика полиомиелита является ключевым аспектом в борьбе с этой опасной инфекцией. Основным методом профилактики является вакцинация, которая позволяет создать иммунитет к вирусу полиомиелита и предотвратить его распространение. Вакцинация против полиомиелита проводится в рамках национальных программ иммунизации и рекомендована всем детям, а также взрослым, находящимся в группе риска.
Существует два основных типа вакцин против полиомиелита: инактивированная полиомиелитная вакцина (ИПВ) и оральная полиомиелитная вакцина (ОПВ). ИПВ содержит убитые вирусы и вводится инъекционно, что делает ее безопасной для людей с ослабленным иммунитетом. ОПВ, в свою очередь, содержит ослабленные живые вирусы и принимается перорально, что позволяет создать более широкий иммунный ответ и способствует формированию коллективного иммунитета.
Вакцинация против полиомиелита обычно начинается в раннем детстве, с первой дозы, вводимой в возрасте 2 месяцев. В большинстве стран рекомендуется проводить несколько доз вакцины в течение первых лет жизни, а также ревакцинацию в более старшем возрасте, особенно для тех, кто планирует поездки в регионы с высоким уровнем заболеваемости.
Важно отметить, что вакцинация не только защищает индивидуального человека, но и способствует формированию коллективного иммунитета, что в свою очередь помогает предотвратить вспышки заболевания в обществе. Вакцинация является особенно важной в странах, где полиомиелит все еще распространен, а также для людей, работающих в медицинских учреждениях или в условиях, где существует риск заражения.
Несмотря на высокую эффективность вакцин, некоторые люди могут не получить достаточный иммунный ответ, что делает их уязвимыми к инфекции. Поэтому важно регулярно проводить мониторинг состояния здоровья населения и поддерживать высокий уровень вакцинации, чтобы избежать повторных вспышек полиомиелита.
Кроме вакцинации, профилактика полиомиелита включает в себя меры по улучшению санитарных условий, доступу к чистой воде и образованию населения о путях передачи вируса. Эти меры помогают снизить риск заражения и распространения вируса в сообществах.
Таким образом, вакцинация и профилактические меры играют решающую роль в контроле и искоренении полиомиелита, обеспечивая защиту как отдельных людей, так и всего общества в целом.
Вопрос-ответ
Что произойдет, если взрослый человек заболеет полиомиелитом?
Симптомы варьируются от легких гриппоподобных проявлений до угрожающего жизни паралича. Менее чем в 1% случаев полиомиелит вызывает необратимый паралич рук, ног или дыхательных мышц. От 5% до 10% людей, заболевших паралитическим полиомиелитом, умирают. Физические симптомы могут появиться через 15 лет и более после первого заражения полиомиелитом.
Как сейчас лечат полиомиелит?
Полиомиелит невозможно вылечить, но можно предотвратить. Единственный способ ― вакцинация с обязательным соблюдением требований к проведению профилактических прививок. Вакцинация от полиомиелита входит в национальный календарь обязательных прививок России. Проводится перорально в несколько этапов.
Советы
СОВЕТ №1
Обратите внимание на вакцинацию. Полиомиелит можно предотвратить с помощью вакцинации. Убедитесь, что вы и ваши близкие получили все необходимые прививки, особенно если вы планируете поездки в регионы с высоким риском заболевания.
СОВЕТ №2
Следите за симптомами. Если вы заметили такие симптомы, как слабость в конечностях, мышечные боли или лихорадку, не откладывайте визит к врачу. Раннее обращение за медицинской помощью может значительно улучшить прогноз.
СОВЕТ №3
Поддерживайте иммунную систему. Здоровый образ жизни, включая сбалансированное питание, регулярные физические нагрузки и достаточный сон, поможет укрепить вашу иммунную систему и снизить риск инфекций, включая полиомиелит.
СОВЕТ №4
Изучите информацию о лечении. Если у вас диагностирован полиомиелит, обсудите с врачом все доступные методы лечения, включая реабилитацию и физиотерапию, которые могут помочь восстановить функции мышц и улучшить качество жизни.